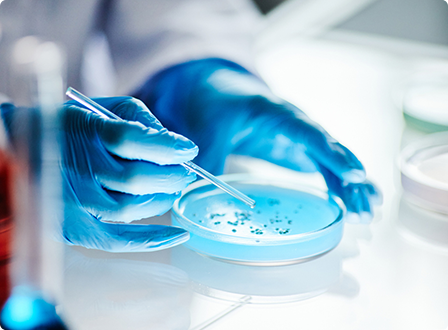

Empowering Your Research & Engineering with
Innovation, Accuracy, and Consistency.
Assign your R&D projects and technical challenges to the POINTVALUES team, and stay hassle free
and assured every step of the way, if you work in Chemical, Environmental, and Energy sectors.



Choose POINTVALUES To:
- Equip your research and engineering team with user friendly tools, dedicated technical support, comprehensive training, reliable accessories, enhanced safety, and long term guarantees.
- Receive precise and easy test, monitoring, control in perfect compliance with Canadian, U.S., and international safety standards, delivering equipment and solutions that meet or exceed regulatory requirements.
- Benefit from the support of a dedicated team of experts committed to solving your technical and research challenges.

Explore Our Product Categories
Our range of lab instruments encompasses a diverse array of measurement, data collection, and analysis instruments,
catering to laboratory, industrial, bench, pilot, and field testing needs.
Expert Consulting & Industry Solutions
With POINTVALUES as your partner, you gain a strategic ally committed
to innovation, compliance, and long term success.
POINTVALUES, multidisciplinary team of engineers, scientists, and skilled technicians brings deep expertise across research, development, and industrial problem solving.
Our team is ready to support both industries and emerging startups in clean energy, environmental innovation, and sustainability with:
- Commercializing a concept,
- Solving a technical bottleneck,
- Support for R&D activities,
- Assisting chemical formulation,
- Technical troubleshooting,
- Process development.
- Navigating available funding opportunities and support programs from government agencies and non-profit organizations.

Contact Us
Let’s Discuss
Your Next Move
1271 Soball St. Coquitlam, BC V3E 0C6
Our Office
ezabihi@pointvalues.co
wdeng@pointvalues.co
Email Us
+1-778 878-1690
+1-604418-3760
Call Us